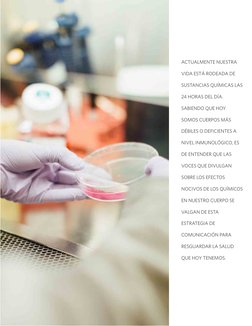
ACTUALMENTE NUESTRA 
VIDA ESTÁ RODEADA DE 
SUSTANCIAS QUÍMICAS LAS 
24 HORAS DEL DÍA. 
SABIENDO QUE HOY 
SOMOS CUERPOS MÁS 
D

100% encontró este documento útil (1 voto)
455 vistas35 páginasVerdades sobre la Vida Saludable
Este documento ofrece una guía sobre los dilemas y áreas grises de vivir una vida saludable. Resalta que la industria de la vida saludable puede ser un negocio que crea confusión, y que la nutrición debe ser personalizada. También advierte sobre depender demasiado de soluciones rápidas como suplementos sin hacer cambios en el estilo de vida.
Cargado por
Maria Fernanda Galarza GilDerechos de autor
© © All Rights Reserved
Nos tomamos en serio los derechos de los contenidos. Si sospechas que se trata de tu contenido, reclámalo aquí.
Formatos disponibles
Descarga como PDF, TXT o lee en línea desde Scribd
100% encontró este documento útil (1 voto)
455 vistas35 páginasVerdades sobre la Vida Saludable
Este documento ofrece una guía sobre los dilemas y áreas grises de vivir una vida saludable. Resalta que la industria de la vida saludable puede ser un negocio que crea confusión, y que la nutrición debe ser personalizada. También advierte sobre depender demasiado de soluciones rápidas como suplementos sin hacer cambios en el estilo de vida.
Cargado por
Maria Fernanda Galarza GilDerechos de autor
© © All Rights Reserved
Nos tomamos en serio los derechos de los contenidos. Si sospechas que se trata de tu contenido, reclámalo aquí.
Formatos disponibles
Descarga como PDF, TXT o lee en línea desde Scribd